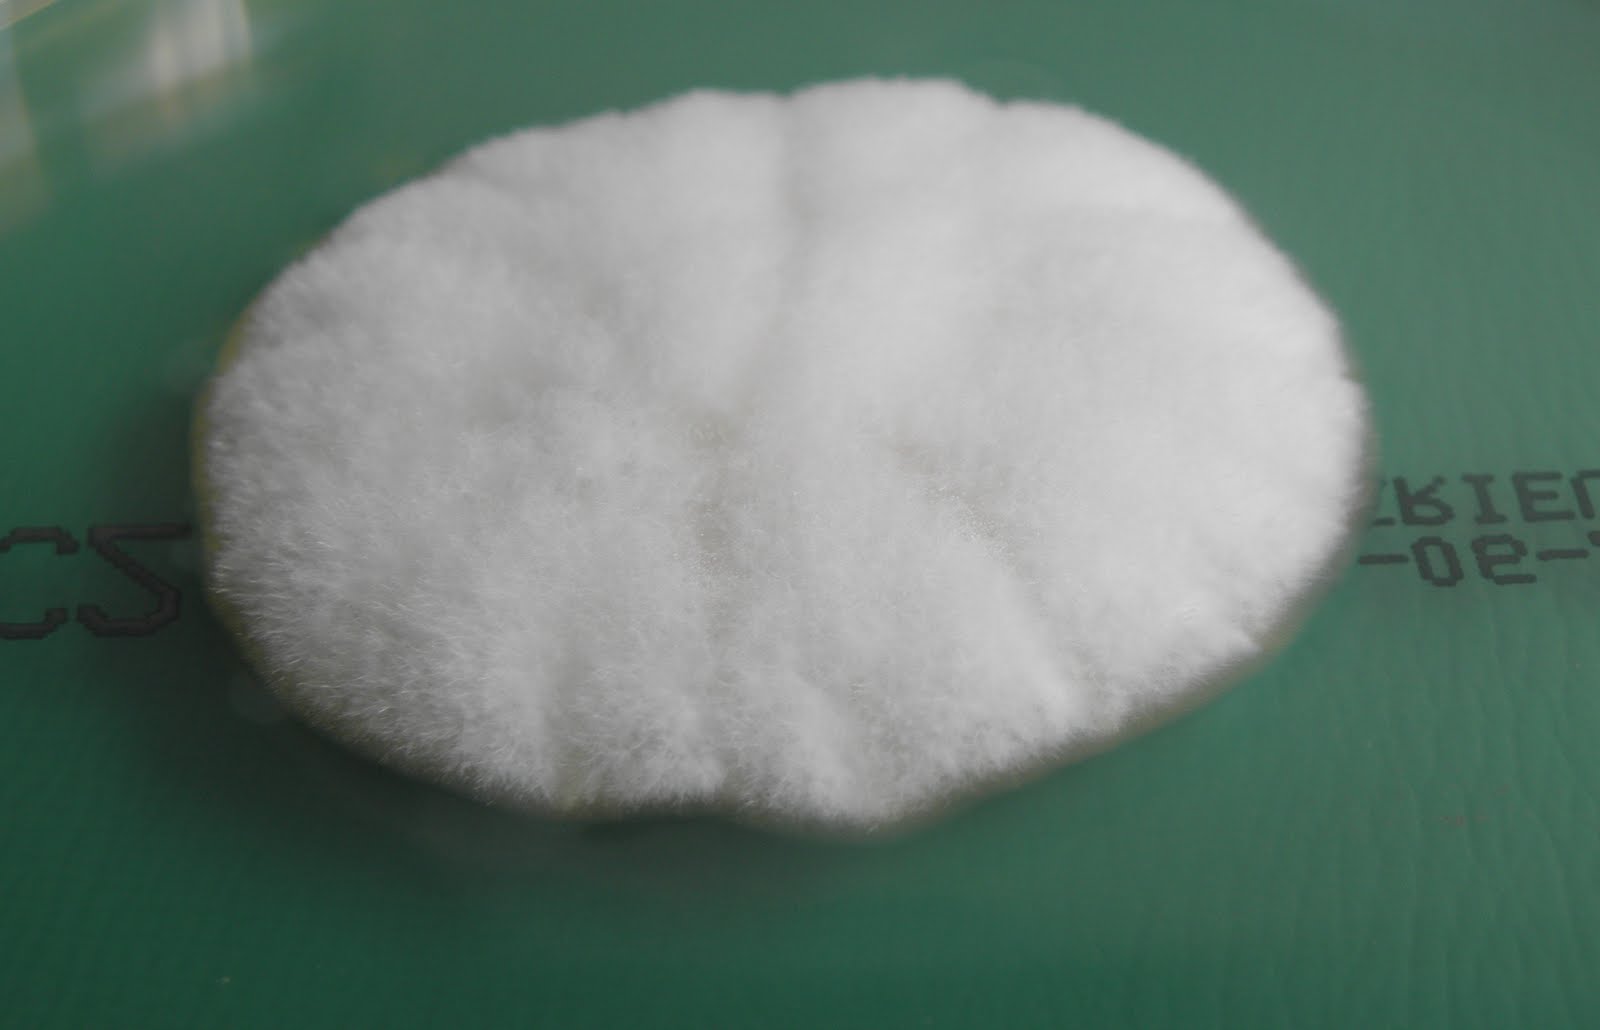

Великаны мира микробов: аспергиллус тубингензис в объективе

Раздел: Природная галерея